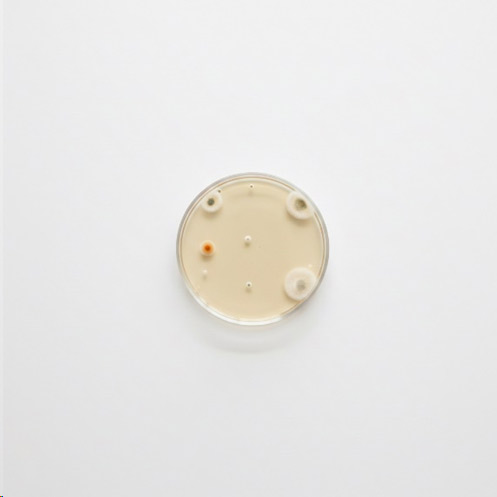
ظروف پلاستیکی آزمایشگاهی

ظروف پلاستیکی آزمایشگاهی

ظروف پلاستیکی آزمایشگاهی یکی از پرکاربردترین ابزارها در آزمایشگاهها هستند که برای نگهداری، مخلوط کردن و انتقال مواد مختلف به کار می روند. این ظروف به دلیل مزایای خاص خود مانند سبکی، مقاومت در برابر شکستگی، هزینه کمتر و قابلیت استفاده در آزمایش های مختلف به یک انتخاب عالی برای بسیاری از آزمایشگاهها تبدیل شده اند. در این مقاله سایت فروشگاه نیکو به بررسی انواع مختلف ظروف پلاستیکی آزمایشگاهی، ویژگیها و کاربردهای هر کدام می پردازیم.
اهمیت پلاستیک در آزمایشگاه ها
در آزمایشگاههای شیمیایی ظروف پلاستیکی بسیار کاربردی هستند, خصوصا وقتی کار روی محلول های نسبتا پایدار صورت می گیرد، یا وقتی ایمنی، سرعت، و صرفه جویی مهم اولویت است:
- برای نگهداری و جابه جایی معرف ها و محلول ها در حجم بالا، پلاستیک (بطری ها، ورک فلاکس، تانک کوچک) گزینه ای اقتصادی و ایمن است.
- در آزمایش هایی که نیازی به حرارت مستقیم یا واکنش شدید شیمیایی ندارند, مثلاً رقیق سازی، نگهداری، آماده سازی محلول, پلاستیک مناسب است.
- در مواقعی که حجم نمونه بالا است پلاستیک یکبار مصرف مثل پلیت یکبار مصرف ۸ سانت یا ظروف چندبار مصرف با قابلیت استریل سریع، کار را ساده تر میکند.
- برای کاهش ریسک شکستگی، ریختن مواد شیمیایی، آسیب به کاربر یا آلودگی محیط, پلاستیک به مراتب امنتر از شیشه است.
اما اگر آزمایش شما شامل دمای بالا، ارزیابی حساس یا حلالهای قوی است, بهتر است از پلاستیک مناسب (مثلPP ) یا شیشه استفاده کنید.
مزایا و معایب پلاستیک در آزمایشگاه
مزایای ظروف پلاستیکی آزمایشگاهی
- سبکی و مقاومت در برابر شکستگی: پلاستیک بسیار سبک تر از شیشه است. این ویژگی باعث شده است تا در محیطهای شلوغ یا آموزشی که خطر شکستگی و جراحت وجود دارد، پلاستیک کاربردی و ایم نتر باشد.
- مقرون به صرفه بودن: پلاستیک معمولاً ارزانتر از شیشه است؛ برای کاربردهای روزمره، مصرف بالا یا ظروف یکبار مصرف، هزینه بسیار مناسبتری دارد.
- یکبار مصرف / استریل: بسیاری از ظروف پلاستیکی,مثل تیوبهای سانتریفیوژ، نوک پیپت، پتری دیشها و …به صورت یکبار مصرف طراحی شدهاند؛ این یعنی دیگر نیازی به شستوشوی مداوم نیست و ریسک آلودگی برطرف میشود. برای آزمایشهایی که حساس به آلودگی میباشند پلاستیک انتخابی منطقی است.
- انعطافپذیری در طراحی: پلاستیک قابل قالبگیری در اشکال و اندازههای متنوع است؛ این تنوع باعث میشود طیف وسیعی از اقلام, اعم از بطریها و تیوبها تا صفحات میکروپلیت و پیپتها با پلاستیک تولید شوند.
- مقاومت شیمیایی و قابلیت اتوکلاو (برای بعضی پلاستیکها): برخی پلاستیکها مثل Polypropylene (PP) مقاومت خوبی نسبت به مواد شیمیایی دارند و قابلیت تحمل دما تا حدود ۱۲۱ درجه سلسیوس را دارا هستند؛ یعنی میتوانند اتوکلاو شوند و برای کارهای آزمایشگاهی حساس مناسباند.
معایب ظروف پلاستیکی آزمایشگاهی
- مقاومت حرارتی محدودتر نسبت به شیشه: بسیاری از پلاستیک ها تحمل دمای بالا را ندارند؛ بنابراین برای واکنشهایی که نیاز به حرارت زیاد یا گرمایش مستقیم دارند، پلاستیک مناسب نیست!
- دقت کمتر در اندازهگیری حجمی: اگر آزمایشی نیاز به دقت بالای حجم مایع (مثل تیتراسیون، اندازهگیری دقیق) دارد, ظروف شیشهای معمولاً بهتر هستند؛ پلاستیک ممکن است در مقابل تغییرات دما یا تنش، مقداری تغییر شکل دهد و دقت را کاهش دهد.
- حساسیت به حلالها و برخی مواد خورنده یا آلی: برخی پلاستیکها در برابر حلالهای آلی یا مواد شیمیایی خاص مقاوم نیستند و ممکن است دچار آسیب یا واکنش نامطلوب شوند.
- زیان زیستی: ظروف یکبار مصرف پلاستیکی در مقایسه با ظروف چندبار مصرف (شیشه) از نظر زیستمحیطی مضر تر هستند.
انواع ظروف پلاستیکی آزمایشگاهی
-
بشر پلاستیکی
بشر پلاستیکی یا Plastic Beaker یکی از پرکاربرد ترین ظروف آزمایشگاهی است که در بسیاری از آزمایشها برای مخلوط کردن، گرم کردن، یا نگهداری محلولها استفاده میشود. این ظروف معمولاً از پلیپروپیلن (PP) یا پلیاتیلن (PE) ساخته میشوند که ویژگیهای خوبی مانند مقاومت در برابر مواد شیمیایی و قابلیت تحمل دماهای پایین را دارند. بشرهای پلاستیکی در اندازههای مختلف تولید میشوند و دارای طراحی خاصی هستند که به راحتی میتوانند مایعات را منتقل کنند یا محلولها را هم بزنند.
- ویژگیها:
- مناسب برای مخلوط کردن، رقیقسازی و نگهداری محلولها
- مقاوم در برابر ضربه و شکستگی
- مناسب برای آزمایشهایی که به دقت بالای اندازهگیری نیاز ندارند
- میتوانند در دمای پایین استفاده شوند اما برای دمای بالا مناسب نیستند.
-
فلاسک
فلاسک (Plastic Erlenmeyer Flask) به شکل مخروطی طراحی شده است و برای مخلوط کردن محلول ها یا ذخیره مایعات در آزمایشگاه استفاده میشود. این ظرف دارای گردن باریک است که به راحتی میتوان آن را بسته نگه داشت و از پاشیدن مواد جلوگیری کرد. ارلن پلاستیکی معمولاً از پلی پروپیلن (PP) ساخته میشود و به دلیل مقاومت در برابر مواد شیمیایی و ضربه، برای آزمایشگاههای صنعتی، آموزشی و تحقیقاتی بسیار مناسب است.
- ویژگیها:
- طراحی خاص برای جلوگیری از پاشیدن مواد
- مناسب برای واکنش های شیمیایی که نیاز به همزدن دارند
- مقاوم در برابر ضربه و شکستن
- مناسب برای آزمایش هایی که نیاز به دقت زیاد در اندازه گیری حجم ندارند.
-
استوانه مدرج پلاستیکی
استوانه مدرج پلاستیکی یا Plastic Graduated Cylinder یکی از دقیقترین ظروف آزمایشگاهی است که برای اندازهگیری حجم مایعات استفاده میشود. این ظروف معمولاً از پلیپروپیلن (PP) ساخته میشوند که میتوانند در برابر ضربه و آسیب مقاوم باشند. استوانههای مدرج به دلیل طراحی خاص خود، دقت بالاتری در اندازهگیری حجم نسبت به بشر دارند و برای آزمایشهایی که نیاز به دقت دارند بسیار مناسب هستند.
- ویژگیها:
- مناسب برای اندازهگیری دقیق حجم مایعات
- مقاوم در برابر ضربه و شکستگی
- مناسب برای آزمایشهای دقیق حجمسنجی
- شفافیت مناسب برای مشاهده تغییرات مایعات
-
لوله آزمایش
لوله آزمایش (Plastic Test Tube) یکی از ظروف پرکاربرد است که در آزمایشگاههای شیمیایی و بیولوژیکی برای انجام آزمایشها و نگهداری نمونه ها در حجم کم استفاده میشود. این لولهها هم معمولاً از پلیپروپیلن (PP) یا پلیاستایرن (PS) ساخته میشوند و به دلیل سبک بودن، شفافیت خوب و مقاومت در برابر شکستگی، انتخاب مناسبی برای محیطهای آزمایشگاهی هستند.
- ویژگیها:
- مناسب برای نگهداری نمونهها و انجام آزمایشهای شیمیایی کوچک
- مقاوم در برابر ضربه و شکستگی
- شفاف برای مشاهده محتویات
- میتوانند به راحتی استریل شوند و برای استفاده یکبار مصرف مناسب هستند.
-
لوله های سانتریفیوژ پلاستیکی
لوله های سانتریفیوژ (Plastic Centrifuge Tubes) برای استفاده در دستگاههای سانتریفیوژ طراحی شدهاند. این لوله ها بدلیل مقاومت بالا در برابر نیروی گریز از مرکز، به راحتی میتوانند در سانتریفیوژهایی با سرعت بالا استفاده شوند. این لوله ها برای ذخیره نمونههای بیولوژیکی، شیمیایی و دارویی مناسب هستند و در اندازههای مختلف موجود میباشند.
- ویژگیها:
- مقاومت بالا در برابر نیروی گریز از مرکز
- مقاوم در برابر مواد شیمیایی و دما
- قابلیت استریلیتی و استفاده یکبار مصرف.
-
پتری دیش
پتری دیش (Plastic Petri Dish) یا انواع پلیت یکبار مصرف استریل یکی از ظروف حیاتی در آزمایشگاههای میکروبیولوژی است که برای کشت میکروارگانیسم ها، سلول ها یا باکتری ها به کار میرود. این ظروف معمولا از پلی استایرن (PS) ساخته میشوند که به دلیل شفافیت بالا برای مشاهده رشد میکروب ها بسیار مناسب هستند. پتری دیش های پلاستیکی معمولا برای استفاده یکبار مصرف طراحی میشوند و به راحتی میتوانند استریل شوند.
- ویژگیها:
- شفافیت بالا برای مشاهده کشت میکروبی
- مناسب برای کشت سلولی و مشاهده تغییرات میکروبی
- میتوانند به راحتی استریل شوند
-
پیپت پلاستیکی
پیپتها (Plastic Pipette) برای انتقال دقیق مایعات در حجم های کوچک استفاده میشوند. پیپتهای پلاستیکی به دلیل ارزان بودن، سبک بودن و مقاوم بودن در برابر شکستگی، در آزمایشگاهها کاربرد گسترده ای دارند. پیپت های پلاستیکی معمولا از پلی پروپیلن (PP) یا پلی اتیلن (PE) ساخته میشوند و در انواع مختلفی از پیپت های دستی تا پیپت های اتوماتیک موجود هستند.
- ویژگیها:
- مناسب برای انتقال دقیق مایعات
- مقاوم در برابر شکستگی
- قابل استفاده یکبار مصرف یا چندبار مصرف
- دقت در انتقال مایعات به حجمهای کوچک
-
بطری های پلاستیکی آزمایشگاهی
بطری های پلاستیکی آزمایشگاهی یا Plastic Laboratory Bottles برای نگهداری مایعات و مواد شیمیایی در آزمایشگاهها طراحی شدهاند. این بطریها که مقاوم در برابر مواد شیمیایی هستند, برای نگهداری محلولها یا معرفها استفاده میشوند. این بطریها بهویژه در آزمایشگاههای شیمیایی و دارویی کاربرد دارند.
- ویژگیها:
- مناسب برای نگهداری محلولها و معرفهای شیمیایی
- مقاوم در برابر ضربه و شکستگی
- قابلیت تحمل برخی از حلال های شیمیایی
- مناسب برای ذخیره سازی طولانی مدت.
ظروف پلاستیکی آزمایشگاهی به دلیل مزایای بی شمار خود، از جمله سبکی، مقاومت در برابر شکستگی، هزینه پایین، و قابلیت استفاده در شرایط مختلف، در بسیاری از آزمایشگاهها جایگزین ظروف شیشهای و فلزی شدهاند. انتخاب ظرف مناسب بسته به نوع آزمایش، مواد شیمیایی استفاده شده، نیاز به دقت اندازه گیری و دما، و مسائل ایمنی متفاوت است.
استفاده از ظروف پلاستیکی برای آزمایش هایی که نیاز به دقت کمتری دارند یا در شرایط خاصی مانند محیطهای آموزشی یا صنعتی انجام میشوند، بسیار کارآمد و ایمن است. اما برای آزمایشهایی که نیاز به دقت بالا، دماهای زیاد یا تعامل با مواد خورنده دارند، استفاده از ظروف شیشهای یا فلزی میتواند انتخاب بهتری باشد.
-
محیط کشت آماده
اسپری ترمیم کننده و ضدعفونی کننده زخم حیوانات رواهیل سپت – حجم ۵۰ میلی لیتر
۷۳۴.۶۰۰تومان افزودن به سبد خریدنمره ۰ از ۵